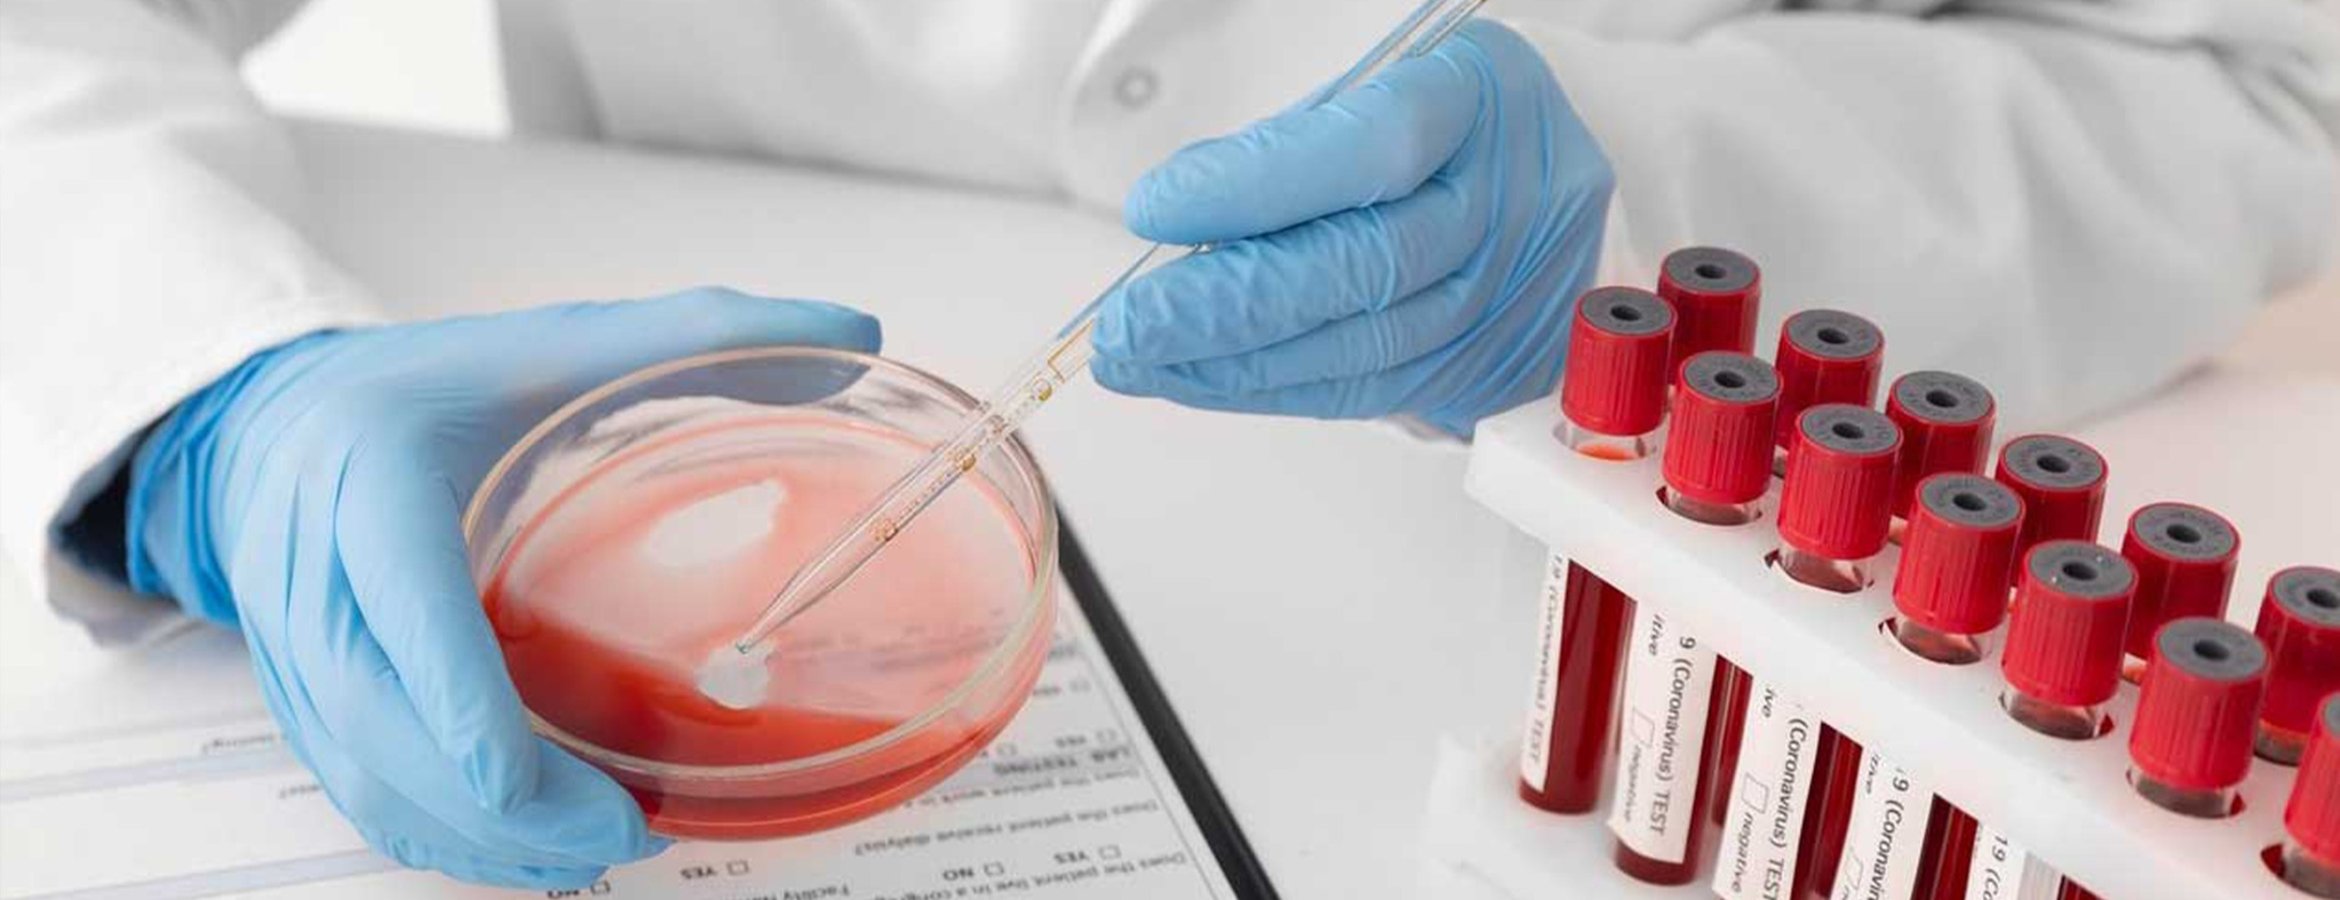

Kan gruplarının kanser üzerindeki etkisi araştırıldı
Biruni Üniversitesi Tıp Fakültesi Hastanesi Onkoloji Uzmanı Prof. Dr. Türkan Öztürk Topcu, Tayvan'da yapılan bir araştırmada, kan grubu A'nın mide kanseri riski üzerindeki etkisinin daha kapsamlı şekilde doğrulandığını belirtti.
Hastaneden yapılan açıklamada paylaşılan araştırmaya göre, kan grupları ile kanser riski arasında anlamlı bir ilişki bulunuyor. Tayvan'da 339 bin 432 kişi üzerinde yapılan çalışma, kan grubu A olan bireylerde mide kanseri insidansının ve mortalitesinin arttığını ortaya koydu. Araştırma, pankreas kanseri riskinin tüm A, B ve AB kan gruplarında arttığını gösterdi.
Açıklamada görüşlerine yer verilen Türkan Öztürk Topcu, kan grubu A'nın mide kanseriyle ilişkilendirilmesinin uzun yıllardır bilindiğini aktararak, "Çalışmanın gösterdiği gibi, kan grubu A'nın mide kanseri riski üzerindeki etkisi daha kapsamlı şekilde doğrulanmış oldu. Bu, kanserin erken teşhis ve tedavisinde önemli bir ipucu olabilir." ifadelerini kullandı.
Mide kanseriyle ilişkili faktörlerden biri olarak "helicobacter pylori" enfeksiyonunu vurgulayan Topcu, enfeksiyonunun, mide kanseri gelişiminde önemli bir faktör olduğunu kaydetti.
Topcu, özellikle kan grubu A olan bireylerin, enfeksiyona daha duyarlı olabileceğine işaret ederek, "Ancak, bu ilişkinin mekanizmalarını daha iyi anlayabilmek için daha fazla araştırma yapılması gerektiği kanaatindeyim." değerlendirmesini yaptı.
- "Genetik yapısı, yaşam tarzı ve alışkanlıklar, riski etkileyebiliyor"
Kan grubu B'nin pankreas kanseri insidansı ve mortalitesi üzerindeki etkisinin göze çarpıcı olduğunu anlatan Topcu, bulgunun nedeninin hala netleşmediğine dikkati çekti.
Topcu, kan grupları ile kanser riski arasındaki ilişkinin yalnızca genetik faktörlerden değil, çevresel etmenlerden de etkilendiğini belirterek, şunları kaydetti:
"Kan grupları, genetik bir özellik olmanın yanı sıra, çevresel faktörler ve yaşam tarzıyla da etkileşime giriyor. Kanser riski, sadece kan grubuna dayanarak tahmin edilemez. Her bireyin genetik yapısı, yaşam tarzı ve alışkanlıkları da bu riski etkileyebiliyor."
Araştırmanın, bulgularının kanserin erken teşhis ve kişiselleştirilmiş tedavi yöntemlerinin geliştirilmesinde önemli bir rol oynayabileceğini kaydeden Topcu, "Bu tür büyük ölçekli çalışmalar, kanserin risk faktörlerini daha iyi anlamamıza yardımcı olabilir ve farklı kanser türlerinde kişiye özel tedavi yaklaşımlarının gelişmesine olanak sağlayabilir." ifadesini kullandı.
Kan gruplarıyla kanser riski arasındaki ilişkinin, özellikle Asya gibi genetik farklılıkların yoğun olduğu bölgelerde daha fazla araştırılması gerektiğini vurgulayarak, "Farklı coğrafyalardaki genetik çeşitlilik, bu tür araştırmalarda önemli bir rol oynayabilir. Bu sebeple, ABO kan grubu ve kanser arasındaki ilişkiyi daha iyi anlamak için global çapta yapılacak çalışmalar büyük önem taşıyor." değerlendirmesinde bulundu.
Yasal Uyarı: Yayınlanan köşe yazısı/haberin tüm hakları Turkuvaz Medya Grubu'na aittir. Kaynak gösterilse dahi köşe yazısı/haberin tamamı özel izin alınmadan kullanılamaz.
Ancak alıntılanan köşe yazısı/haberin bir bölümü, alıntılanan habere aktif link verilerek kullanılabilir. Ayrıntılar için lütfen tıklayın.